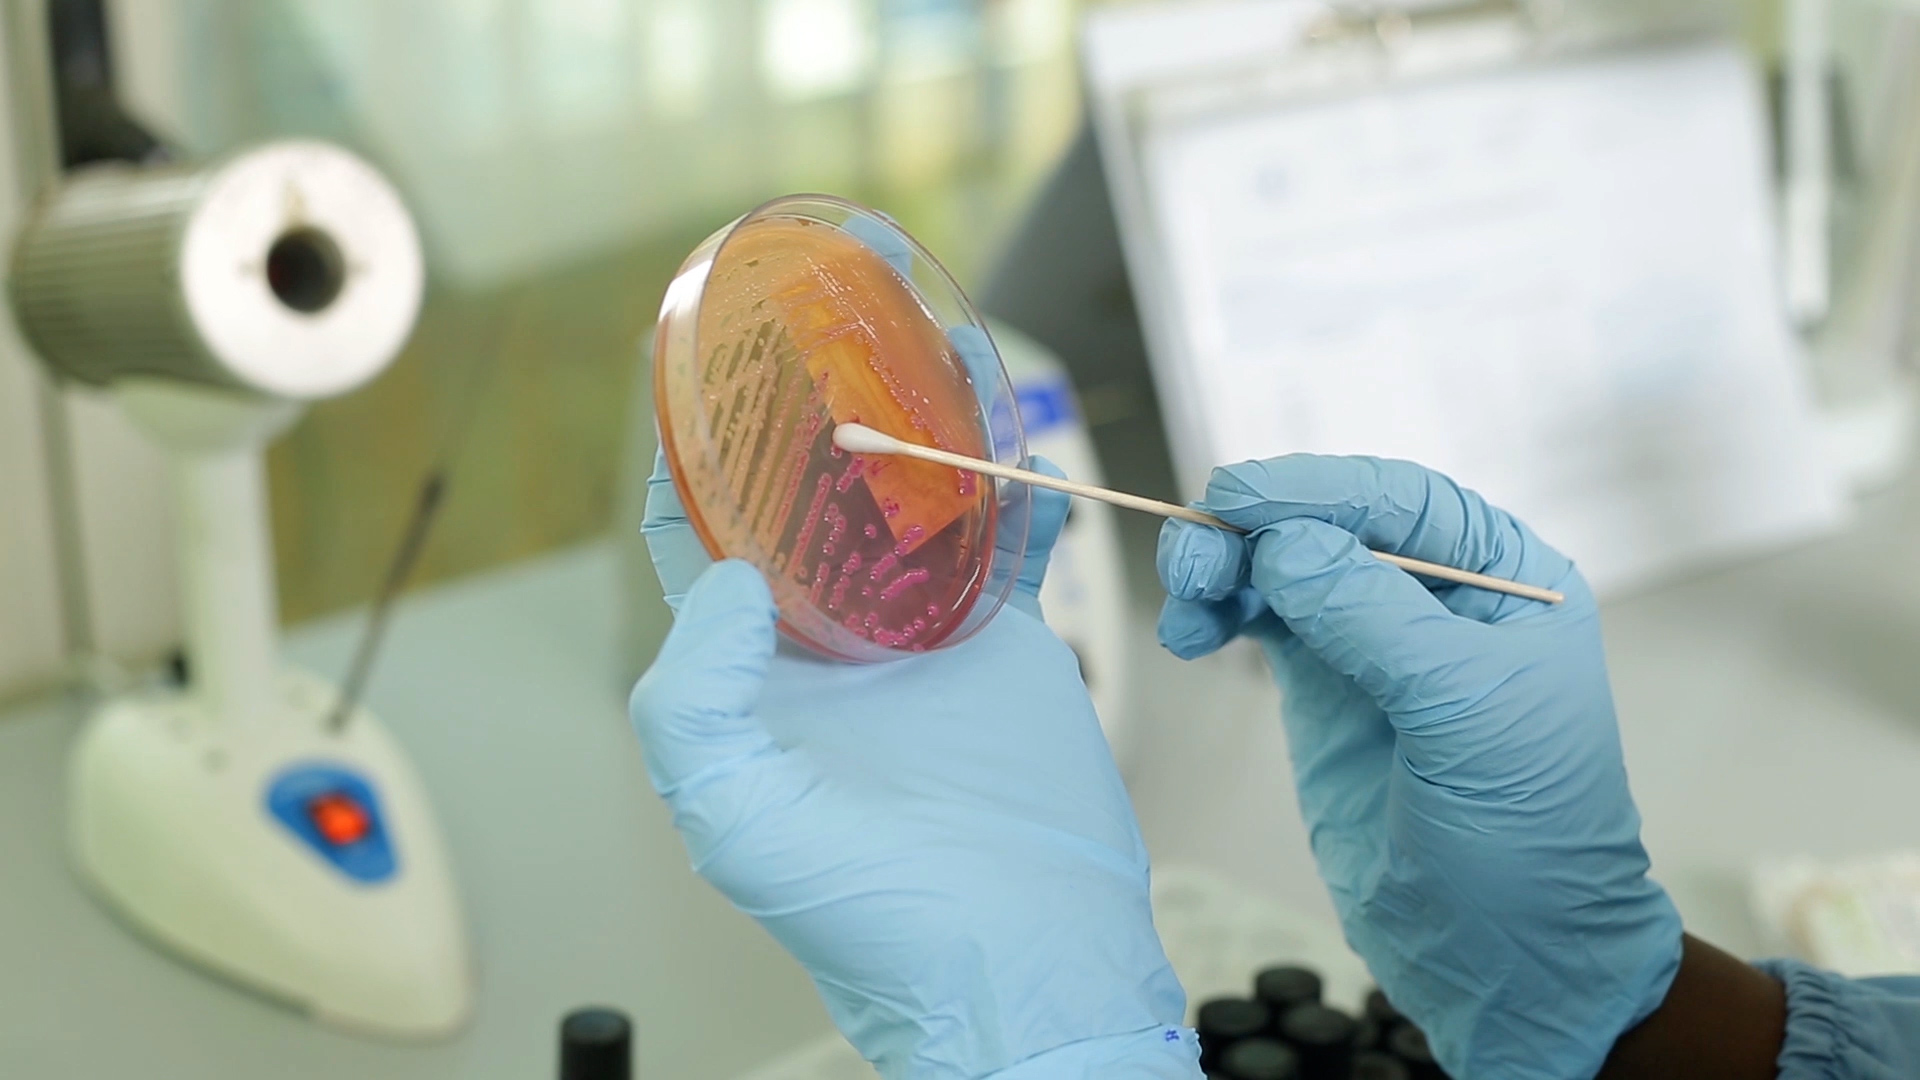
Microbiology

Laboratory Testing Services
At ICL, we offer a comprehensive range of diagnostic testing services designed to support accurate clinical decisions and improve patient outcomes. Our laboratories adhere to JCI standards and employ advanced technology, expert analysis, and a rigorous quality management system to deliver precise and timely results.

Hematology and Coagulation
Accurate evaluation of blood and clotting parameters to aid in diagnosing anemia, infections, bleeding, and clotting disorders.
Learn More
Chemistry
Comprehensive metabolic, renal, and liver function profiling for the management of acute and chronic diseases.
Learn More
Immunoassays
High-sensitivity detection of hormones, tumor markers, and infectious diseases through automated immunoassay platforms.
Learn More
Molecular Tests
Cutting-edge molecular diagnostics for infectious disease detection, genetic testing, and oncology applications.
Learn More
Microbiology
Accurate identification of infectious agents and antimicrobial susceptibility testing to guide effective treatment.
Learn More
Paternity Testing
Confidential and accurate DNA-based relationship testing through our referral partnership with Labcorp (USA).
Learn More